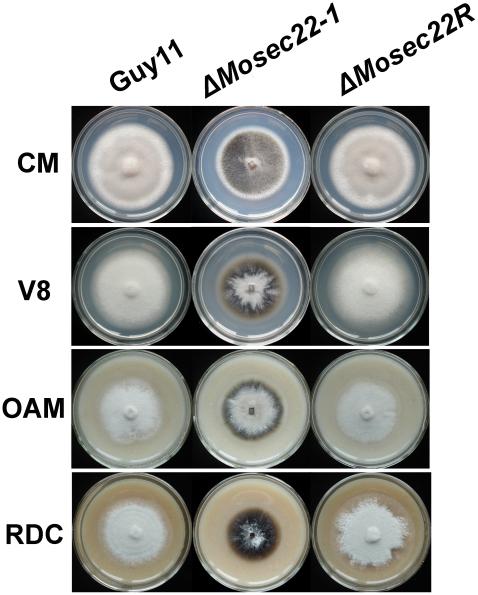

R-SNARE 同源物 MoSec22 对于稻瘟病菌的分生孢子发生、细胞壁完整性和致病性是必需的。
R-SNARE homolog MoSec22 is required for conidiogenesis, cell wall integrity, and pathogenesis of Magnaporthe oryzae.
机构信息
Department of Plant Pathology, College of Plant Protection, Nanjing Agricultural University, and Key Laboratory of Monitoring and Management of Crop Diseases and Pest Insects, Ministry of Agriculture, Nanjing, China.
出版信息
PLoS One. 2010 Oct 6;5(10):e13193. doi: 10.1371/journal.pone.0013193.
Soluble N-ethylmaleimide-sensitive factor attachment protein receptor (SNARE) proteins mediate intracellular vesicle fusion, which is an essential cellular process of the eukaryotic cells. To investigate the role of SNARE proteins in the rice blast fungus Magnaporthe oryzae, MoSec22, an ortholog of Saccharomyces cerevisiae SNARE protein Sec22, was identified and the MoSEC22 gene disrupted. MoSec22 restored a S. cerevisiae sec22 mutant in resistance to cell wall perturbing agents, and the ΔMosec22 mutant also exhibited defects in mycelial growth, conidial production, and infection of the host plant. Treatment with oxidative stress inducers indicated a breach in cell wall integrity, and staining and quantification assays suggested abnormal chitin deposition on the lateral walls of hyphae of the ΔMosec22 mutant. Furthermore, hypersensitivity to the oxidative stress correlates with the reduced expression of the extracellular enzymes peroxidases and laccases. Our study thus provides new evidence on the conserved function of Sec22 among fungal organisms and indicates that MoSec22 has a role in maintaining cell wall integrity affecting the growth, morphogenesis, and virulence of M. oryzae.
可溶性 N-乙基马来酰亚胺敏感因子附着蛋白受体(SNARE)蛋白介导细胞内囊泡融合,这是真核细胞的基本细胞过程。为了研究 SNARE 蛋白在稻瘟病菌 Magnaporthe oryzae 中的作用,鉴定了酿酒酵母 SNARE 蛋白 Sec22 的同源物 MoSec22,并敲除了 MoSEC22 基因。MoSec22 恢复了对细胞壁扰动剂有抗性的酿酒酵母 sec22 突变体,而 ΔMosec22 突变体也表现出菌丝生长、分生孢子产生和宿主植物侵染的缺陷。用氧化应激诱导剂处理表明细胞壁完整性受损,染色和定量分析表明菌丝侧壁上的几丁质沉积异常。此外,对氧化应激的敏感性与细胞外酶过氧化物酶和漆酶表达的降低相关。因此,我们的研究为 Sec22 在真菌生物中的保守功能提供了新的证据,并表明 MoSec22 在维持细胞壁完整性方面发挥作用,影响稻瘟病菌的生长、形态发生和毒力。